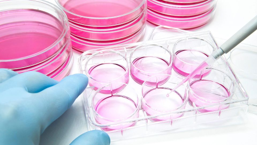
Cell Biology

CELL BIOLOGY
CELL BIOLOGY
Cell biology is the study of the structure and function of the cell, encompasses many research areas. Allianz BioInnovation provides reliable consumables, supplements and kits for cell transfection, cell culture, cell analysis, etc.